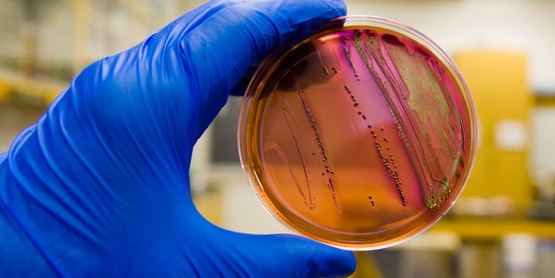

Food Safety
Each year in the U.S., one out of every six Americans gets sick from eating contaminated food. Knowing good food safety practices is important in preventing foodborne illnesses. The following websites provide in-depth, reliable information about how you can keep you and your family safe with proper food safety practices.
- Partnership for Food Safety Education: www.fightbac.org
- Center for Disease Control and Prevention: https://www.cdc.gov/foodsafety/index.html
The following are excellent resources for understanding the core four practices for food safety:
- Clean: Core-Four-Practices-Fact-Sheets-Clean-7.pdf
- Separate: Core-Four-Practices-Fact-Sheets-Separate.pdf
- Cook: Core-Four-Practices-Fact-Sheets-Cook-2.pdf
- Chill: Core-Four-Practices-Fact-Sheets-Chill.pdf
Cornell Cooperative Extension of Broome County offers ServSafe classes and certifications. Contact us to learn more.
Contact
Ann Supa
4-H UNITY and Nutrition Educator
ams364@cornell.edu
(607) 772-8953
Last updated October 15, 2020